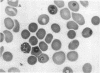

Abstract
The polyunsaturated fatty acids docosahexaenoic acid (C22:6,n-3), eicosapentaenoic acid, arachidonic acid, and linoleic acid caused marked in vitro growth inhibition of Plasmodium falciparum, assessed by a radiometric assay. In contrast, negligible parasite killing was seen with oleic acid or docosanoic acid. Parasite killing was significantly increased when oxidized forms of polyunsaturated fatty acids were used. Antioxidants greatly reduced the fatty acid-induced killing. Mice infected with P. berghei and treated for 4 d with C22:6,n-3 showed marked reduction in parasitemia. The anemia associated with the infection was also alleviated by treatment with C22:6,n-3. The data provide new information that could be explored in order to develop new strategies in malaria treatment.
Full text
PDF






Images in this article
Selected References
These references are in PubMed. This may not be the complete list of references from this article.
- Allison A. C., Eugui E. M. The role of cell-mediated immune responses in resistance to malaria, with special reference to oxidant stress. Annu Rev Immunol. 1983;1:361–392. doi: 10.1146/annurev.iy.01.040183.002045. [DOI] [PubMed] [Google Scholar]
- Cenedella R. J., Jarrell J. J., Saxe L. H. Lipid synthesis in vivo from 1-14C-oleic acid and 6-3H-glucose by intraerythrocytic Plasmodium berghei. Mil Med. 1969 Sep;134(10):1045–1055. [PubMed] [Google Scholar]
- Clark I. A., Butcher G. A., Buffinton G. D., Hunt N. H., Cowden W. B. Toxicity of certain products of lipid peroxidation to the human malaria parasite Plasmodium falciparum. Biochem Pharmacol. 1987 Feb 15;36(4):543–546. doi: 10.1016/0006-2952(87)90364-9. [DOI] [PubMed] [Google Scholar]
- Clark I. A., Hunt N. H., Butcher G. A., Cowden W. B. Inhibition of murine malaria (Plasmodium chabaudi) in vivo by recombinant interferon-gamma or tumor necrosis factor, and its enhancement by butylated hydroxyanisole. J Immunol. 1987 Nov 15;139(10):3493–3496. [PubMed] [Google Scholar]
- Clark I. A., Hunt N. H., Butcher G. A., Cowden W. B. Inhibition of murine malaria (Plasmodium chabaudi) in vivo by recombinant interferon-gamma or tumor necrosis factor, and its enhancement by butylated hydroxyanisole. J Immunol. 1987 Nov 15;139(10):3493–3496. [PubMed] [Google Scholar]
- Dockrell H. M., Playfair J. H. Killing of Plasmodium yoelii by enzyme-induced products of the oxidative burst. Infect Immun. 1984 Feb;43(2):451–456. doi: 10.1128/iai.43.2.451-456.1984. [DOI] [PMC free article] [PubMed] [Google Scholar]
- Esterbauer H., Cheeseman K. H., Dianzani M. U., Poli G., Slater T. F. Separation and characterization of the aldehydic products of lipid peroxidation stimulated by ADP-Fe2+ in rat liver microsomes. Biochem J. 1982 Oct 15;208(1):129–140. doi: 10.1042/bj2080129. [DOI] [PMC free article] [PubMed] [Google Scholar]
- Ferrante A., Kumaratilake L., Rzepczyk C. M., Dayer J. M. Killing of Plasmodium falciparum by cytokine activated effector cells (neutrophils and macrophages). Immunol Lett. 1990 Aug;25(1-3):179–187. doi: 10.1016/0165-2478(90)90112-4. [DOI] [PubMed] [Google Scholar]
- Ferrante A., Rzepczyk C. M., Allison A. C. Polyamine oxidase mediates intra-erythrocytic death of Plasmodium falciparum. Trans R Soc Trop Med Hyg. 1983;77(6):789–791. doi: 10.1016/0035-9203(83)90290-0. [DOI] [PubMed] [Google Scholar]
- Haidaris C. G., Haynes J. D., Meltzer M. S., Allison A. C. Serum containing tumor necrosis factor is cytotoxic for the human malaria parasite Plasmodium falciparum. Infect Immun. 1983 Oct;42(1):385–393. doi: 10.1128/iai.42.1.385-393.1983. [DOI] [PMC free article] [PubMed] [Google Scholar]
- Hsiao L. L., Howard R. J., Aikawa M., Taraschi T. F. Modification of host cell membrane lipid composition by the intra-erythrocytic human malaria parasite Plasmodium falciparum. Biochem J. 1991 Feb 15;274(Pt 1):121–132. doi: 10.1042/bj2740121. [DOI] [PMC free article] [PubMed] [Google Scholar]
- Jensen J. B., Boland M. T., Akood M. Induction of crisis forms in cultured Plasmodium falciparum with human immune serum from Sudan. Science. 1982 Jun 11;216(4551):1230–1233. doi: 10.1126/science.7043736. [DOI] [PubMed] [Google Scholar]
- Kim R. S., LaBella F. S. Comparison of analytical methods for monitoring autoxidation profiles of authentic lipids. J Lipid Res. 1987 Sep;28(9):1110–1117. [PubMed] [Google Scholar]
- Kumaratilake L. M., Ferrante A., Rzepczyk C. M. Tumor necrosis factor enhances neutrophil-mediated killing of Plasmodium falciparum. Infect Immun. 1990 Mar;58(3):788–793. doi: 10.1128/iai.58.3.788-793.1990. [DOI] [PMC free article] [PubMed] [Google Scholar]
- Kumaratilake L. M., Ferrante A., Rzepczyk C. The role of T lymphocytes in immunity to Plasmodium falciparum. Enhancement of neutrophil-mediated parasite killing by lymphotoxin and IFN-gamma: comparisons with tumor necrosis factor effects. J Immunol. 1991 Jan 15;146(2):762–767. [PubMed] [Google Scholar]
- Lijana R. C., Williams M. C. Tetramethylbenzidine--a substitute for benzidine in hemoglobin analysis. J Lab Clin Med. 1979 Aug;94(2):266–276. [PubMed] [Google Scholar]
- Mendis K. N., Naotunne T. D., Karunaweera N. D., Del Giudice G., Grau G. E., Carter R. Anti-parasite effects of cytokines in malaria. Immunol Lett. 1990 Aug;25(1-3):217–220. doi: 10.1016/0165-2478(90)90118-a. [DOI] [PubMed] [Google Scholar]
- Naotunne T. S., Karunaweera N. D., Del Giudice G., Kularatne M. U., Grau G. E., Carter R., Mendis K. N. Cytokines kill malaria parasites during infection crisis: extracellular complementary factors are essential. J Exp Med. 1991 Mar 1;173(3):523–529. doi: 10.1084/jem.173.3.523. [DOI] [PMC free article] [PubMed] [Google Scholar]
- Ohnishi S. T., Ohnishi N., Oda Y., Katsuoka M. Prostaglandin derivatives inhibit the growth of malarial parasites in mice. Cell Biochem Funct. 1989 Apr;7(2):105–109. doi: 10.1002/cbf.290070205. [DOI] [PubMed] [Google Scholar]
- Ohnishi S. T., Sadanaga K. K., Katsuoka M., Weidanz W. P. Effects of membrane acting-drugs on plasmodium species and sickle cell erythrocytes. 1989 Nov 23-Dec 19Mol Cell Biochem. 91(1-2):159–165. doi: 10.1007/BF00228091. [DOI] [PubMed] [Google Scholar]
- Poulos A., Robinson B. S., Ferrante A., Harvey D. P., Hardy S. J., Murray A. W. Effect of 22-32 carbon n-3 polyunsaturated fatty acids on superoxide production in human neutrophils: synergism of docosahexaenoic acid with f-met-leu-phe and phorbol ester. Immunology. 1991 May;73(1):102–108. [PMC free article] [PubMed] [Google Scholar]
- Rock R. C. Incorporation of 14 C-labelled fatty acids into lipids of rhesus erythrocytes and Plasmodium knowlesi in vitro. Comp Biochem Physiol B. 1971 Dec 15;40(4):893–906. doi: 10.1016/0305-0491(71)90035-6. [DOI] [PubMed] [Google Scholar]
- Rockett K. A., Targett G. A., Playfair J. H. Killing of blood-stage Plasmodium falciparum by lipid peroxides from tumor necrosis serum. Infect Immun. 1988 Dec;56(12):3180–3183. doi: 10.1128/iai.56.12.3180-3183.1988. [DOI] [PMC free article] [PubMed] [Google Scholar]
- Sherman I. W. Biochemistry of Plasmodium (malarial parasites). Microbiol Rev. 1979 Dec;43(4):453–495. doi: 10.1128/mr.43.4.453-495.1979. [DOI] [PMC free article] [PubMed] [Google Scholar]
- Stevenson M. M., Ghadirian E. Human recombinant tumor necrosis factor alpha protects susceptible A/J mice against lethal Plasmodium chabaudi AS infection. Infect Immun. 1989 Dec;57(12):3936–3939. doi: 10.1128/iai.57.12.3936-3939.1989. [DOI] [PMC free article] [PubMed] [Google Scholar]
- Taverne J., Tavernier J., Fiers W., Playfair J. H. Recombinant tumour necrosis factor inhibits malaria parasites in vivo but not in vitro. Clin Exp Immunol. 1987 Jan;67(1):1–4. [PMC free article] [PubMed] [Google Scholar]
- Thumwood C. M., Hunt N. H., Cowden W. B., Clark I. A. Antioxidants can prevent cerebral malaria in Plasmodium berghei-infected mice. Br J Exp Pathol. 1989 Jun;70(3):293–303. [PMC free article] [PubMed] [Google Scholar]
- Trager W., Jensen J. B. Human malaria parasites in continuous culture. Science. 1976 Aug 20;193(4254):673–675. doi: 10.1126/science.781840. [DOI] [PubMed] [Google Scholar]
- Vial H. J., Thuet M. J., Broussal J. L., Philippot J. R. Phospholipid biosynthesis by Plasmodium knowlesi-infected erythrocytes: the incorporation of phospohlipid precursors and the identification of previously undetected metabolic pathways. J Parasitol. 1982 Jun;68(3):379–391. [PubMed] [Google Scholar]